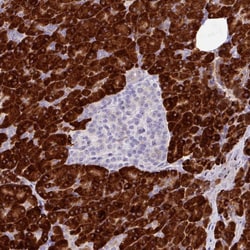
Invitrogen RGS21 Polyclonal Antibody 100 &mu;L; Unconjugated:Antibodies,

missing translation for 'onlineSavingsMsg'
Learn More
Learn More
Invitrogen™ RGS21 Polyclonal Antibody


Rabbit Polyclonal Antibody
Brand: Invitrogen™ PA562699
This item is not returnable.
View return policy
Description
Immunogen sequence: FPRFLKSEIY KKLVNSQQVP NHK Highest antigen sequence identity to the following orthologs: Mouse - 96%, Rat - 78%.
Regulator of G-protein signaling (RGS) proteins contain an 120 amino acid conserved domain, termed the RGS domain, that acts as a GTPase-activating protein that acts to reduce the signal transmitted by the receptor-activated G-alpha subunit. RGS21 is a recently identified member of this family that has been reported to be selectively expressed in subpopulations of taste bud cells and co-expressed with bitter and sweet transduction components such as alpha-gusticin, phospholipase Cbeta2, T1R2/T1R3 sweet taste receptors and T2R bitter taste receptors. Other reports indicate that RGS21 is more widely expressed. Binding assays demonstrate that RGS21 binds alpha-gusticin in a conformation-dependent manner and may do the same with T1R receptors, suggesting that RGS21 may play a role in sweet and bitter taste transduction processes.
Specifications
| RGS21 | |
| Polyclonal | |
| Unconjugated | |
| RGS21 | |
| EG624910; regulator of G-protein signaling 21; regulator of G-protein signalling 21; RGS21 | |
| Rabbit | |
| Antigen Affinity Chromatography | |
| RUO | |
| 431704 | |
| Store at 4°C short term. For long term storage, store at -20°C, avoiding freeze/thaw cycles. | |
| Liquid |
| Immunohistochemistry (Paraffin) | |
| 0.05 mg/mL | |
| PBS with 40% glycerol and 0.02% sodium azide; pH 7.2 | |
| Q2M5E4 | |
| RGS21 | |
| Recombinant protein corresponding to Human RGS21. Recombinant protein control fragment (Product #RP-99839). | |
| 100 μL | |
| Primary | |
| Human | |
| Antibody | |
| IgG |
Product Content Correction
Your input is important to us. Please complete this form to provide feedback related to the content on this product.
Product Title
Spot an opportunity for improvement?Share a Content Correction